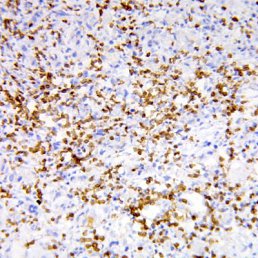
Daniel, Донецк

|
Кого вы ищите?
|
Всего найдено: 2298

Алька
37 года,Донецк

Саша
34 года,Донецк

Виктория
41 года,Донецк

Andrei
37 года,Донецк

Андрей
Донецк

Макс
39 года,Донецк

Юлия
Донецк

Юльчик
47 года,Донецк

Антон
40 года,Донецк

Никикта
Донецк

Sasha
47 года,Донецк

Kimi3
41 года,Донецк
-

Дима
Донецк

Антон
36 года,Донецк

Женя
Донецк

Тулия
57 года,Донецк

Алекс
58 года,Донецк

Даниил
Донецк

Нюра
Донецк

Ира
37 года,Донецк

Vanila
28 года,Донецк

Дмитрий
40 года,Донецк

Лерко
39 года,Донецк

Януся
43 года,Донецк

Красилова
37 года,Донецк

Алекс
43 года,Донецк

Лёлик
Донецк

Алексей
44 года,Донецк

Nola
42 года,Донецк

Игорь
39 года,Донецк

Светлана
47 года,Донецк
Daniel
Донецк

Иван
Донецк

Aleks
38 года,Донецк

Uhbif
Донецк

Серега
Донецк

Женька
44 года,Донецк

Хельга
54 года,Донецк

Женя
Донецк

Кристина
36 года,Донецк

Дима
34 года,Донецк

Олясик
35 года,Донецк

Оля
Донецк

Паша
Донецк

Виталик
39 года,Донецк

Сергей
39 года,Донецк

Тиана
43 года,Донецк

Инга
48 года,Донецк

Юся
34 года,Донецк

Елена
Донецк
|